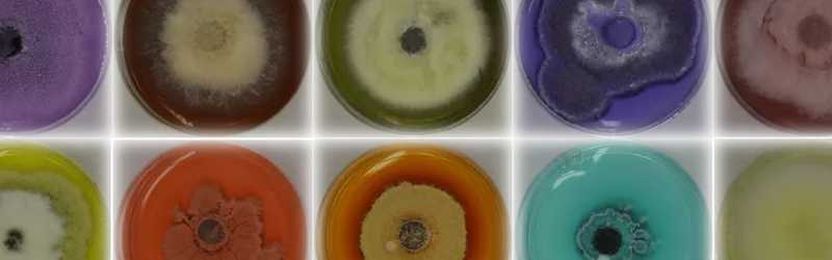

About Probuild:
Probuild is located at 1781 S 4650th W in Glendale - Salt Lake City, UT - Salt Lake County and is a business listed in the categories Building Materials General, Building Supplies & Materials, Lumber & Other Building Materials, Other Building Material Dealers and Other Building Materials. After you do business with Probuild, please leave a review to help other people and improve hubbiz. Also, don't forget to mention Hubbiz to Probuild.
Categories: Building Materials General, Building Supplies & Materials, Lumber & Other Building Materials, Other Building Material Dealers and Other Building Materials
- AISC
- Builders
- Building Products
- Building Supplies
- Cabinet Shop
- Cast Stone
- Ceramic
- Closers
- Concrete
- Contractors
- Counters
- Design Services
- Dirt
- Electrical
- Fiberglass
- Fireplaces
- Flooring
- Frames
- Galleries
- Handrails
- Hardware
- Inc.
- Kitchen Tops
- Kitchens
- Marble
- Materials
- Moldings
- Paint
- Paneling
- Patio Stone
- Rock
- Roofing
- Roofing Materials
- Sand
- Showplace
- Showroom
- SHUTTERS
- Timber
- Trusses
Please, help us improve the listing for Probuild.
We picked the most popular labels that other businesses under the category Building Materials General
are using.
We would like to confirm which of them is featured by Probuild.
It doesn't require registration. But if you sign-up on Hubbiz, it will have more
weight on our algorithms and in the future, we can, with your permission, inform
the business that you helped improve their listing (in case they decide to show their
appreciation).
There's no need to be perfect. A few more labels will already help other people find the right information.
We appreciate your contribution.